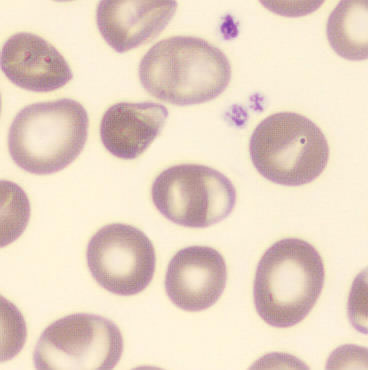
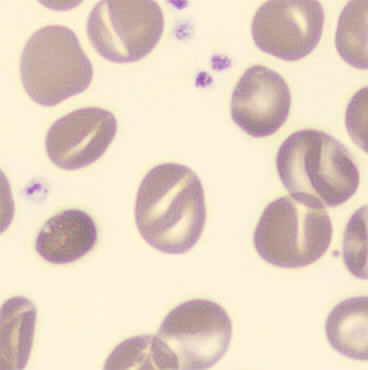
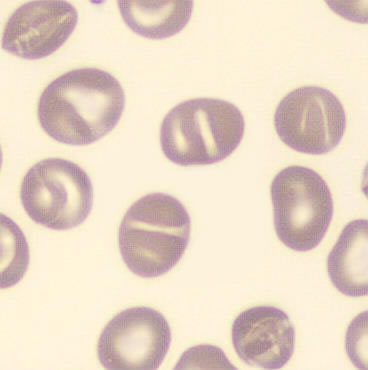
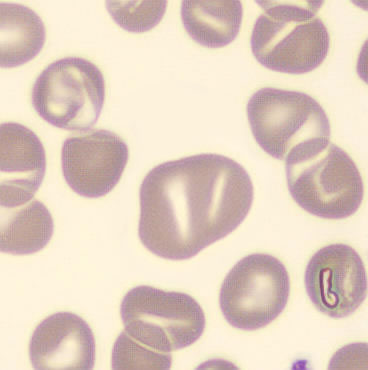
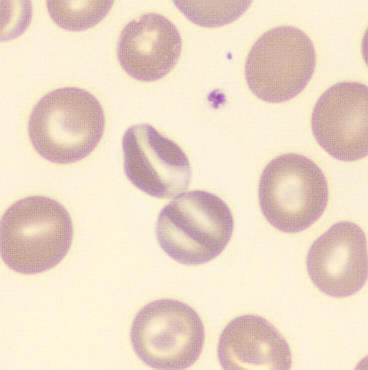

Knizocyte
Synonyme: Pinched cell
Ein Knizocyt ist eine (seltene) rote Blutzelle mit zwei oder mehr hellen Bereichen, die durch einen schmalen, hämoglobinreichen Streifen getrennt sind, wodurch die Zelle „zusammengequetscht“ (“pinched cell”) aussieht. Er ist ein wichtiger Hinweis auf die südostasiatische Ovalozytose (SAO), kann aber auch bei Störungen des Cholesterin- oder Fettstoffwechsels vorkommen, etwa bei akuten oder chronischen Lebererkrankungen.